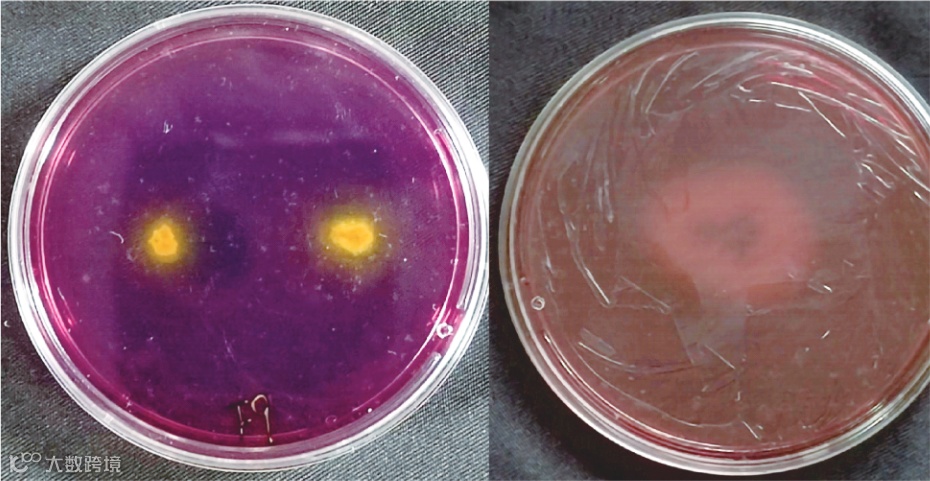

磷是植物生长发育不可缺少的营养元素之一,并参与植物体内的各种代谢过程,然而我国的磷肥当季利用率很低,仅有10%~20%。此外,土壤中的铁、铝、钙、镁离子含量较高,容易与施入的磷肥结合被固定形成难溶性磷,而农户为增加作物产量而过量的施入磷肥造成了一系列的环境污染问题。因此,为了减少磷肥的施用,通过筛选高效解磷菌株应用于肥料而制成的微生物肥料,显著提高磷肥利用率并减少了对生态环境的污染。

海南省地处热带,气候条件优越,适合哈密瓜种植。但种植区沙质土壤基础肥力差,不保水,不保肥的特点,使得种植户盲目施肥,造成不必要的浪费和环境污染。因此,伍巧慧等试验筛选适应于海南热区的高温根际促生菌,并探究菌株对哈密瓜的生长发育及土壤特性的影响。
实验设计
哈密瓜定植后,每隔10d接种一次菌液,接种量为20mL/株。30d后测定植株SPAD值(叶绿素相对含量)、鲜重和干重、叶绿素、叶片数、株高等农艺性状。采集土壤样品测定土壤酸碱度,有机质、碱解氮、有效磷、速效钾含量及土壤酸性磷酸酶活性。
耐高温解磷菌株的筛选与鉴定
从哈密瓜根际土壤中共分离纯化1株细菌,表1表明,3株真菌均可在改良难溶性无机磷培养基上产黄色解磷圈,解磷圈与菌落直径比值(D/d)为1.39~1.91。各菌株解磷量在69.13~457.69μg/mL之间,解磷量最高的是F9菌株,达到457.69μg/mL,其次是F70菌株,为369.38μg/mL。发酵液pH值在4.77~6.84,同时,发酵液pH值越低,解磷量越高。
表1 菌株促生能力测定

注:不同小写字母表示处理间差异显著(P<0.05)。下同;+表示菌株吲哚乙酸(IAA)定性结果为阳性,++表示阳性结果且颜色深。
4株菌株均具有产IAA能力,各菌株IAA分泌量为1.72~15.65μg/mL。其中,F1菌株IAA分泌量15.65μg/mL,显著高于其他菌株。综合考虑菌株的促生能力,选择解磷特性较强的F9菌株作为目标菌株进行下一步研究。

经序列比对,菌株F1、F9、F70与烟曲霉(Aspergillus fumigatus)的序列同源性达到99%,故可确定F1、F9、F70菌株为烟曲霉(图1),菌株B25与创口博德特氏杆菌(Bordetella trematum)的序列同源性达到96%,故可确定B25菌株为创口博德特氏杆菌。

图1菌株F1、F9、F70及B25基于ITS和16SrDNA基因序列构建的系统发育树
注:a为F1、F9、F70菌株;b为B25菌株。
菌株形态特征和生理生化特性
真菌菌株F9开始为棉花絮状,2~3d后转为绿色,生长过程中颜色不断加深,菌落生长速度较快,最后呈深绿色粉末状,分生孢子头柱状,分生孢子梗短,表面平滑,革兰氏染色阳性(图2、表2)。
图2菌株F9及CK菌株在改良难溶性无机磷固体培养基上产生的溶磷圈
表2菌株的形态特征和生化反应

注:+表示菌株生化反应为阳性,-表示菌株生化反应为阴性。
菌株耐高温能力测定
图3为F9菌株在不同温度下24h的生长情况,菌株F9在25~40°C中不断生长,在40°C时达到最高生长点,40~50°C时OD值持续下降,50~55°C间OD值出现上升趋势,F9菌株在30~55°C时OD值比25°C时高,说明菌株F9生长温度高于一般的常温菌。

图3菌株F9在不同温度下的生长状况(24h)
菌株对哈密瓜地上部、地下部
的鲜重和干重累积的影响
由表3可知,与未接菌的对照组相比,接种不同菌液均可在一定程度上提高哈密瓜地上部鲜重、干重和地下部鲜重、干重。其中接种F9菌液,地上部鲜重较CK、F40显著提高了142.94%、26.75%,地上部干重较CK显著提高了23.44%、11.82%,地下部鲜重较CK显著提高了26.00%、13.74%,地下部干重较CK显著提高了4.61%、1.80%。
表3 菌株对哈密瓜生物量累积的影响(g)

菌株对哈密瓜农艺性状的影响
由表4可以看出,与未接种的对照相比,接种F9菌株后哈密瓜的农艺性状均得到显著提高。叶片数、最大叶面宽、茎长、根长、根体积较CK分别显著提高了50.00%、48.65%、124.11%、123.10%、134.62%,叶片数、最大叶面宽、茎长、根长较F40分别显著提高了30.19%、31.20%、35.49%、127.32%,根体积较F40提高了3.39%。
表4 菌株对哈密瓜农艺性状和叶绿素含量的影响

菌株对土壤理化性质及
酸性磷酸酶活性的影响
由表5可以看出,接种不同菌株后,土壤pH值有不同程度的降低,接种菌株F9土壤pH值较CK显著降低了2.03%,较F40降低了1.06%。接种F9菌株后,土壤碱解氮较CK、F40分别显著降低了15.94%、26.09%,接种F9菌株可显著提高土壤有机质含量,较CK、F40分别显著提高了56.74%、67.55%。
表5 菌株对土壤理化性质及磷酸酶活性的影响

接种菌株后,土壤速效钾含量都有不同程度的降低,F9较CK、F40分别降低了15.96%、11.80%。接种F9菌株土壤有效磷含量较CK、F40分别显著提高了33.52%、9.79%。接种F9土壤酸性磷酸酶活性较CK、F40分别显著提高了323.31%、201.07%。

土壤理化性质及土壤酸性磷酸酶活性
与哈密瓜生长相关指标的相关性分析
结果(表6)表明,pH值与哈密瓜植株地上部鲜重、叶片数、最大叶面宽、茎长呈极显著负相关,与地下部鲜重、地上部干重、根体积呈显著负相关。碱解氮与最大叶面宽呈极显著负相关,与叶片数呈显著负相关。有机质含量与哈密瓜植株地上部干重、叶片数、最大叶面宽呈极显著正相关,与地上部鲜重、地下部鲜重、茎长、根长呈显著正相关。
表6 土壤理化性质及土壤酸性磷酸酶活性与哈密瓜生长相关指标的相关性分析

注:*表示在0.01水平(双侧)上显著相关;表示在0.05水平(双侧)上显著相关。
速效钾含量与地上部鲜重、茎长呈显著负相关。有效磷含量与地上部鲜重、地下部鲜重、地上部干重、地下部干重、叶片数、最大叶面宽、茎长、根体积呈显著正相关。土壤酸性磷酸酶活性与哈密瓜植株地上部鲜重、地下部鲜重、地上部干重、叶片数、最大叶面宽、茎长、根长、根体积的相关性达极显著或显著水平,与土壤有机质、有效磷的相关性达极显著水平。

结论
本试验筛选出的耐高温根际促生菌株F9具有强解磷能力和分泌生长素的性能,对哈密瓜生长具有显著促进作用且可提高土壤速效养分含量,进一步改善土壤养分。本研究可为热区哈密瓜微生物菌肥的开发提供理论依据和菌种资源。
引 用
伍巧慧,龚文坤,刘新月,等. 哈密瓜根际耐高温促生菌的筛选及其促生效应研究[J]. 中国土壤与肥料,2023(11):221-228.
——————END——————
版权说明
文案 | 来源 伍巧慧,龚文坤,刘新月,等. 哈密瓜根际耐高温促生菌的筛选及其促生效应研究[J]. 中国土壤与肥料,2023(11):221-228.
图片 | 来源 伍巧慧,龚文坤,刘新月,等. 哈密瓜根际耐高温促生菌的筛选及其促生效应研究[J]. 中国土壤与肥料,2023(11):221-228.
其他图片来源网络,若侵权可联系删除。其它产品图来源光华时代(海南)生物科技有限公司拍摄或设计(不可作其它商用)
本文所有自主文案、图片等如需转载需事先联系光华时代(海南)生物科技有限公司授权,转载需注明来源!





